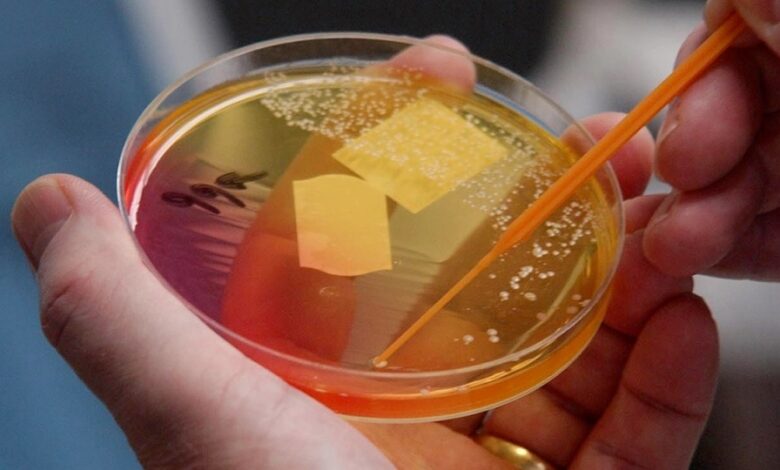
نور درمانی جدید

پخش زنده
امروز: -
یک روش نور درمانی جدید میتواند برخی از بدترین ابر میکروبهای مقاوم به آنتی بیوتیک را که به گفته محققان استرالیایی میتواند برای میلیونها نفر در سراسر جهان خطرناک باشد، از بین ببرد.
به گزارش سرویس وبگردی خبرگزاری صدا و سیما ، این روش درمانی که توسط محققان دانشگاه استرالیای جنوبی ساخته شده است، به طور قابل توجهی باکتریهای استاف طلایی و سودوموناس آئروژینوزا را از بین میبرد. استاف طلایی و سودوموناس آئروژینوزا هر دو باکتریهای بسیار قابل انتقالی هستند که معمولاً روی پوست افراد یافت میشوند، اما اگر وارد خون شوند، میتوانند منجر به سپسیس یا حتی مرگ شوند.
به گفته محمد آواد (Muhammed Awad) پژوهشگر ارشد این مطالعات، بیماران بستری در بیمارستانها به ویژه آنهایی که زخم دارند یا کسانی که از دستگاه تنفس مصنوعی استفاده میکنند، در معرض خطر بیشتری برای ابتلا به این باکتریها بوده و اگرچه آنتی بیوتیکها ممکن است کمک کنند، اما استفاده گسترده از آنها منجر به مقاومت میکروبی میشود که اغلب آنها را بی اثر میکند.
کلایو پرستیج (Clive Prestidge) یکی دیگر از محققان میگوید: فناوری فتودینامیک ما متفاوت عمل کرده و انرژی نور را برای تولید مولکولهای اکسیژن بسیار واکنش پذیر به کار میگیرد که سلولهای میکروبی را ریشه کن میکند و باکتریهای کشنده را بدون آسیب رساندن به سلولهای انسانی از بین میبرد.
پرستیج در ادامه گفت: این فناوری نسبت به آنتی بیوتیکهای معمولی و سایر روشهای نوردرمانی مزایای کلیدی دارد. او گفت: درمان جدید در روغنی انجام میشود که به عنوان لوسیون روی زخم مالیده میشود. هنگامی که نور لیزر به لوسیون اعمال شود، گونههای اکسیژن فعال ایجاد میکند که به عنوان جایگزینی برای آنتی بیوتیکهای معمولی عمل میکند.
پروفسور پرستیج اظهار کرد:ترکیبات فوتواکتیو کنونی از حلالیت ضعیف در آب رنج میبرند که به این معنی است که کاربرد بالینی محدودی دارند.
او تاکید کرد: رویکرد ما از لیپیدهای غذایی ساختن نانوحاملها برای ترکیب فوتواکتیو است که حلالیت و کارایی ضد باکتریایی آن را بسیار فراتر از یک ترکیب فرمول نشده بهبود میبخشد.
پرستیج افزود: این مولکولها چندین سلول باکتری را به طور همزمان هدف قرار داده و از سازگاری و مقاوم شدن باکتریها جلوگیری میکنند. بنابراین، این روش یک درمان بسیار موثرتر و قویتر است.
محققان در خاتمه اضافه میکنند: نکته مهم این است که سلولهای پوست انسان درگیر در روند بهبود زخم، قابلیت زنده مانی بیشتری را نشان دادند در حالی که باکتریهای مقاوم به آنتیبیوتیک به طور کامل از بین رفتند. ابر میکروبهای مقاوم به آنتی بیوتیک سالانه جان میلیونها نفر را در سراسر جهان میگیرند و تأثیر قابل توجهی بر اقتصاد جهانی دارند.